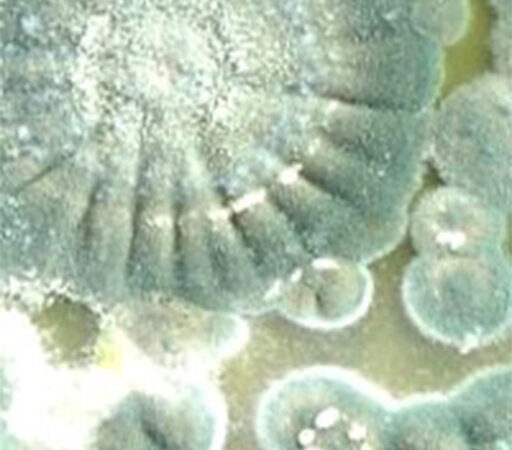

Allergic persons vary in their sensitivities to mold, both as to the amount and the types to which they react. In addition to their allergic properties, certain types of molds, such as Stachybotris chartarum, may produce compounds that have toxic properties, which are called mycotoxins. Mycotoxins are not always produced, and whether a mold produces mycotoxins depends on what the mold is growing on.
Conditions such as temperature, pH, humidity or other unknown factors play an important role. When mycotoxins are present, they occur in both living and dorment mold spores and may be present in materials that have become contaminated with molds. While Stachybotrys is growing, a wet slime layer covers its spores, preventing them from becoming airborne.
However, when the mold dies and dries up, air currents or physical handling can cause spores to become airborne. At present there is no environmental test to determine whether Stachybotrys growth found in buildings is producing toxins. There is also no blood or urine test that can establish if an individual has been exposed to Stachybotrys chartarum spores or its toxins.